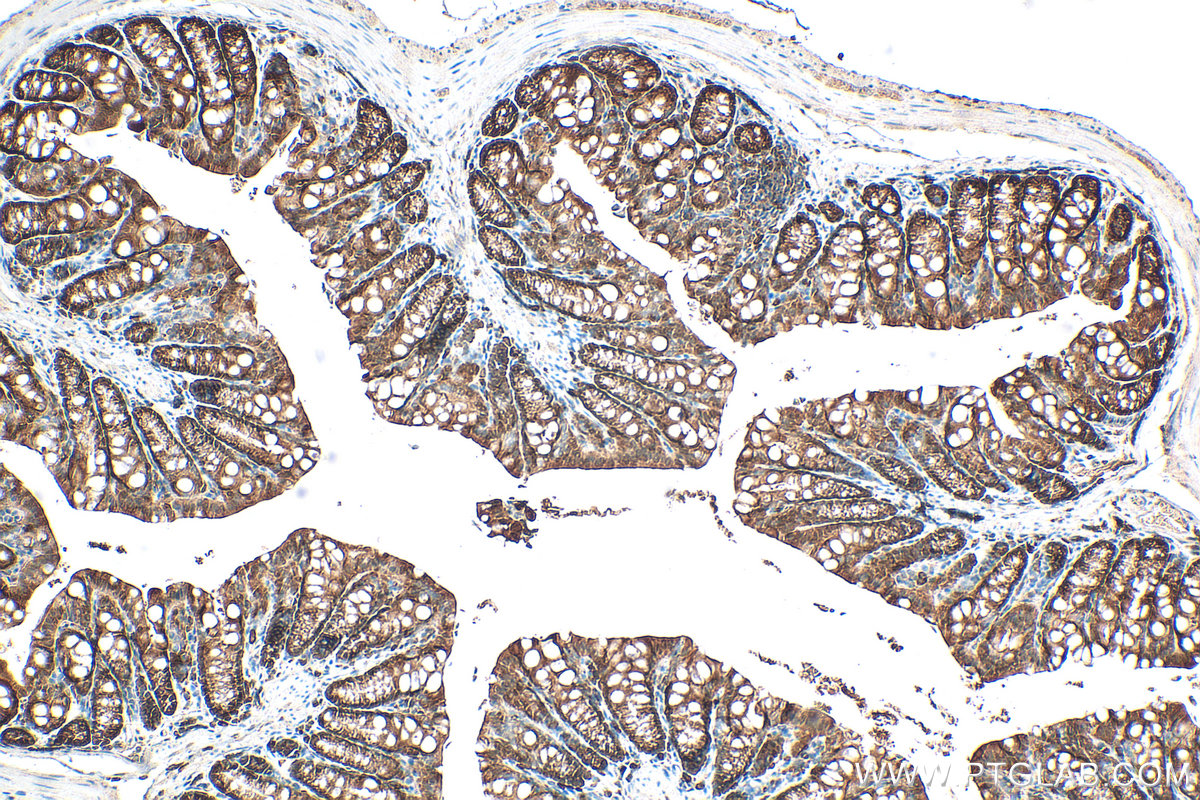
Immunohistochemical analysis of paraffin-embedded mouse colon tissue slide using 30641-1-AP (ASC/TMS1 antibody) at dilution of 1:400 (under 10x lens). Heat mediated antigen retrieval with Tris-EDTA buffer (pH 9.0). IHC staining of mouse colon using 30641-1-AP

验证数据展示
经过测试的应用
| Positive WB detected in | mouse spleen tissue, mouse thymus tissue, rat spleen tissue, rat thymus tissue |
| Positive IHC detected in | mouse colon tissue Note: suggested antigen retrieval with TE buffer pH 9.0; (*) Alternatively, antigen retrieval may be performed with citrate buffer pH 6.0 |
| Positive IF/ICC detected in | MCF-7 cells |
推荐稀释比
| 应用 | 推荐稀释比 |
|---|---|
| Western Blot (WB) | WB : 1:5000-1:50000 |
| Immunohistochemistry (IHC) | IHC : 1:200-1:800 |
| Immunofluorescence (IF)/ICC | IF/ICC : 1:200-1:800 |
| It is recommended that this reagent should be titrated in each testing system to obtain optimal results. | |
| Sample-dependent, Check data in validation data gallery. | |
产品信息
30641-1-AP targets ASC/TMS1 in WB, IHC, IF/ICC, ELISA applications and shows reactivity with mouse, rat samples.
| 经测试应用 | WB, IHC, IF/ICC, ELISA Application Description |
| 文献引用应用 | WB, IF |
| 经测试反应性 | mouse, rat |
| 文献引用反应性 | human, mouse, rat |
| 免疫原 |
CatNo: Ag32519 Product name: Recombinant mouse PYCARD protein Source: e coli.-derived, PGEX-4T Tag: GST Domain: 1-193 aa of NM_023258 Sequence: MGRARDAILDALENLSGDELKKFKMKLLTVQLREGYGRIPRGALLQMDAIDLTDKLVSYYLESYGLELTMTVLRDMGLQELAEQLQTTKEESGAVAAAASVPAQSTARTGHFVDQHRQALIARVTEVDGVLDALHGSVLTEGQYQAVRAETTSQDKMRKLFSFVPSWNLTCKDSLLQALKEIHPYLVMDLEQS 种属同源性预测 |
| 宿主/亚型 | Rabbit / IgG |
| 抗体类别 | Polyclonal |
| 产品类型 | Antibody |
| 全称 | PYD and CARD domain containing |
| 别名 | PYCARD, Apoptosis-associated speck-like protein containing a CARD, Asc, CARD5, masc |
| 计算分子量 | 21KD |
| 观测分子量 | 21-25 kDa |
| GenBank蛋白编号 | NM_023258 |
| 基因名称 | Pycard |
| Gene ID (NCBI) | 66824 |
| RRID | AB_3086379 |
| 偶联类型 | Unconjugated |
| 形式 | Liquid |
| 纯化方式 | Antigen affinity purification |
| UNIPROT ID | Q9EPB4 |
| 储存缓冲液 | PBS with 0.02% sodium azide and 50% glycerol, pH 7.3. |
| 储存条件 | Store at -20°C. Stable for one year after shipment. Aliquoting is unnecessary for -20oC storage. |
背景介绍
PYCARD (PYD and CARD domain containing), also known as ASC and CARD5. The calculated molecular weight of PYCARD is 21 kDa. It is located in cytosol, extracellular region and nucleus. PYCARD is also expressed in several structures, including alimentary system; brain; heart; hemolymphoid system gland; and urinary system. The gene enables identical protein binding activity and protein dimerization activity. Involved in several processes, including activation of cysteine-type endopeptidase activity; positive regulation of cytokine production; and regulation of defense response. It acts upstream of or within several processes, including defense response to Gram-positive bacterium; positive regulation of macromolecule metabolic process; and regulation of autophagy. It is also a part of inflammasome complex. Finally, it orthologous to human PYCARD (PYD and CARD domain containing).
实验方案
| Product Specific Protocols | |
|---|---|
| IF protocol for ASC/TMS1 antibody 30641-1-AP | Download protocol |
| IHC protocol for ASC/TMS1 antibody 30641-1-AP | Download protocol |
| WB protocol for ASC/TMS1 antibody 30641-1-AP | Download protocol |
| Standard Protocols | |
|---|---|
| Click here to view our Standard Protocols |
发表文章
| Species | Application | Title |
|---|---|---|
J Agric Food Chem Ginsenoside Ro Targets BCAT1/2 to Suppress Ferroptosis: A Novel Therapeutic Strategy for Ischemic Cardioprotection | ||
Phytomedicine Total paeony glycoside relieves neuroinflammation to exert antidepressant effect via the interplay between NLRP3 inflammasome, pyroptosis and autophagy. | ||
Phytomedicine Jiangu formula modulates the gut microbiota structure and the NF-κB/NLRP3 signaling pathway to alleviate synovitis. | ||
Immunobiology Liyan Kaiyin Formula relieves reflux pharyngitis by regulating M1 macrophage polarization via the NF-κB/NLRP3 pathway. | ||
Basic Res Cardiol Renal denervation attenuates cardiac dysfunction in HFpEF by inhibiting the ATP-P2X7-NLRP3 inflammasome axis. | ||
Biol Trace Elem Res Salidroside Alleviates Fluoride-Induced Pyroptosis and Developmental Neurotoxicity Through P2X7R/NF-κB/NLRP3 Pathway. |